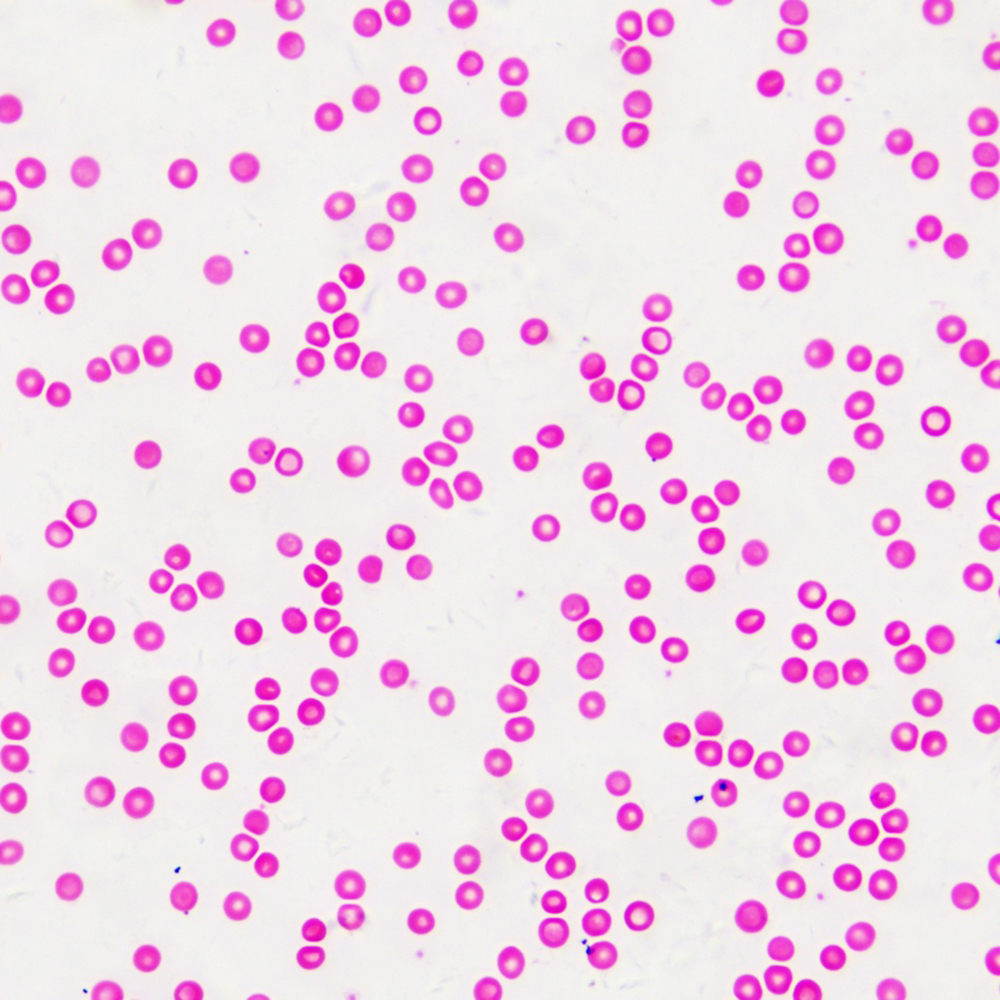

- Інтернет-магазин
- →
- Мікропрепарати
- →
- Bresser
- →
- №2 Animal (30 шт.)
Набір мікропрепаратів BRESSER №2 Animal (30 шт.)
- Самовивіз з магазину в Києві: Безкоштовно!
( забрати 20.04.2026 ) - Кур'єром по Києву: Безкоштовно!
( доставимо 20.04.2026 ) - Нова Пошта: За тарифами
( відправимо 20.04.2026 )
- При отриманні
- Онлайн-оплата
- Переказ IBAN
- Рахунок на оплату
- 14 днів міс. (від виробника)
- 14 днів на обмін/повернення
- Бренд: Bresser (Німеччина)
- Код виробника: #5986000
ОПИС
Набір мікропрепаратів Bresser №2 Animal складається із 30 готових слайдів для біологічних мікроскопів, серед яких можна знайти частини комах та зрізи тканин різних органів. Наявність готових мікропрепаратів заощаджує час, який потрібний для самостійного створення зразків. З даним набором ніяких додаткових підготовок не потрібно, можна починати вивчення прямо "з коробки".
Слайди виготовлені із високоякісних матеріалів та призначені для спостереження в мікроскоп із нижньою підсвіткою. Набір постачається у дерев'яному кейсі, який захищає мікропрепарати від можливих пошкоджень під час зберігання або транспортування.
Рекомендований для використання в освітніх цілях як для дітей, так і школярів.
Набір Bresser №2 Animal (30 шт.) включає наступні зразки:
- Інфузорія-туфелька
- Кон'югація інфузорії-туфельки
- Поділ інфузорії-туфельки
- Евглена
- Поздовжній зріз гідри
- Поперечний зріз гідри
- Поперечний зріз сіменника гідри
- Гідра з зачатком
- Шистосома (самець)
- Шистосома (самка)
- Поперечний зріз яйця аскариди
- Мірацидій шистосоми
- Церкарій шистосоми
- Зріла шистосома
- Цистицерк (личинка стрічкового черв'яка)
- Стрічковий черв'як
- Поперечний зріз самки та самця аскариди
- Мітоз яєць аскариди
- Поперечний зріз дощового черв'яка
- Ротовий апарат бджоли
- Ротовий апарат комара
- Личинка комара звичайного
- Ротовий апарат кімнатної мухи
- Ротовий апарат метелика
- Задня лапка бджоли
- Мураха
- Поперечний зріз зябер молюска
- Поперечний зріз яйця жаби
- Зріз печінки жаби
- Мазок крові голуба
Комплектація:
- Готові слайди (30 шт.)
- Дерев'яний кейс
Габарити:
- Вага у коробці: 451 г
Виробник залишає за собою право вносити зміни до комплектації без попереднього повідомлення.
ХАРАКТЕРИСТИКИ
| Кількість слайдів: | 30 шт. |
| Тематика набору: |
• зоологія • одноклітинні |
| Матеріал слайдів: | скло |
| Матеріал коробки: | дерево |

Напишіть перший!